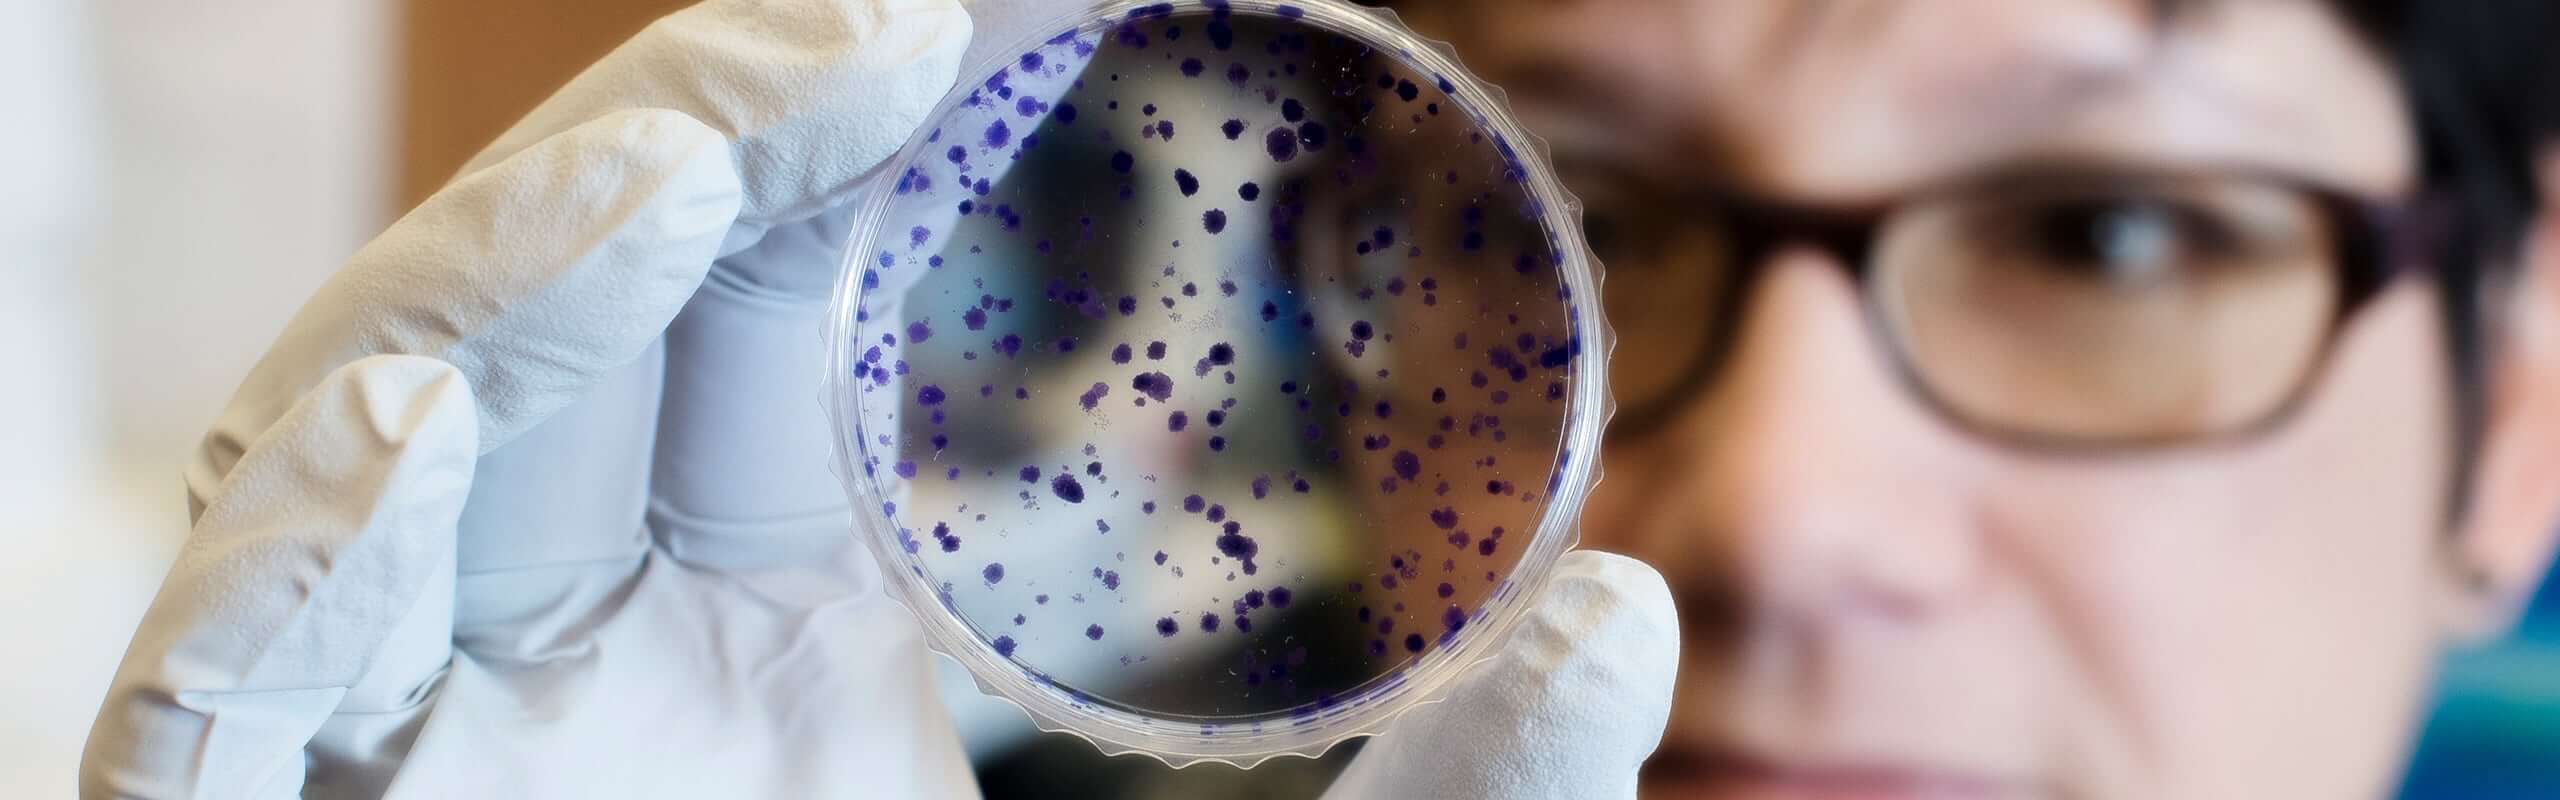

What Is Cancer Biology?
The UAB cancer biology program offers a thorough and comprehensive understanding of cancer cell biology and behavior, including:
- carcinogenesis
- proliferation
- cancer genetics
- the tumor microenvironment
- cell signaling
- cancer immunology
Upon graduation, our students will be able to demonstrate knowledge of current cancer treatments including chemotherapy, radiotherapy, surgery, gene therapy, and personalized approaches to cancer treatment.
Interested In Learning More About
Cancer Biology?
Register below for the Heersink School of Medicine Joint Undergraduate Programs interest session and visit UAB campus.